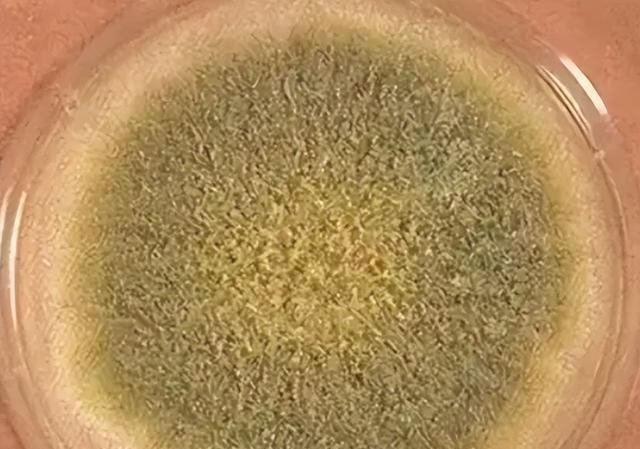
过期的茶叶能喝吗

是不是大家也碰到过这般情形:翻找出一包搁置了五六年的茶叶,闻着并未坏掉,扔掉觉着亏,喝了又害怕出现问题。台岛长庚医院去年收治的一位阿姨,饮用了存放八年的乌龙茶,结果是黄曲霉毒素超标致使急性肝损伤,医生发出警告再晚两天黄疸就降不下去了。几百块的茶叶与几万块的医药费,这笔账真得认真计算计算。
茶叶过期到底有多危险
含水率高、茶中所含的专门的茶多酚特别活跃的绿茶以及清香乌龙这类茶,在常温的状况下,每天都处于氧化变质的进程之中。你推测以为是茶的香气逸散丢失了,然而实际上里面细菌正如同正在举办一场热闹派对时那般活跃。实验人员针对过期的铁观音进行重新烘焙的举措之后再开展检测,发现酵母菌数量依旧多得超出正常范围,那种喝到喉咙产生发紧感觉的“锁喉感”,实际上就是菌丝在黏膜上如同划刀子一样的行为所导致的。
黑茶与红茶看上去较为沉稳,然而一旦遭遇受潮状况,在18个月之后同样会滋生霉菌。只是这些茶叶色泽深邃,凭借肉眼很难察觉到霉菌。其中毒性最强的当属黄曲霉,即便用开水冲泡也根本无法将其烫死,要是长期饮用此类茶叶,患肝癌的风险将会显著提高。千万不要认为没有怪异味道就不存在问题,毕竟有些毒素根本无法通过嗅觉察觉出来有别的味道。

普洱茶放久了真能喝吗
普洱越老越值钱存在前提条件,其前提条件是得“出身好”,此外还得“仓储干净”。云南茶科所的检测表明,渥堆发酵过程中黑曲霉占优势,这种情况下能够压制黄曲霉的生长,不过这是在工厂控温控湿的专业环境里。你家阳台跟厨房柜子温差有二三十度,湿度动不动就爆表,在这样的环境下黑曲霉早就死光了。
因此,存在将普洱茶放成宝贝的情况,然而放成毒药的情况更多。关键在于你是否会存放,若存放不对,那便是在给黄曲霉营造生长环境。2019年,广州有一位茶商送检了自家存放五年的普洱,结果黄曲霉毒素B1超标三倍,整批货物都被全部销毁。千万别拿自己的肝脏去赌那万分之一的运气。
四步判断茶叶能不能留
首先第一步是用手去捏,对于干茶而言,若一捏就碎从而成为粉末状,这乃是底线要求,要是捏起来呈现软塌塌的状态,那就表明茶叶已经受潮了。接着第二步是用鼻子闻,当盖子被打开,在三秒钟之内鼻子有发酸的感觉,又或者闻到土腥味、油哈味,那就应直接毫不犹豫地抛入垃圾桶。然后第三步是用眼睛看,将茶叶倾倒在白纸上,然后仔细查找是否存在绿灰色以外的斑点、白丝以及黑点,一旦看到其中一个,那就是茶叶发霉了。
用开水泡处于第四步,当沸水冲下去之后观察茶汤,要是茶汤呈现混浊状态、表面漂浮着油花,又或者喝上一口会感觉喉咙出现发干发紧的状况,那就得立刻停杯并将其倒掉。这包含的四步之中,倘若有任何一步存在不对劲之处,那么这茶就不能留存了。就算这四步都算是勉强通过了关卡,然而过期茶的香气物质也已经损失了九成还要多,喝起来跟白水基本上没什么差异。
舍不得扔可以怎么办

愣是特别在乎那几百块钱,于是给茶叶来个“转岗”,别往肚子里头灌。用纱布把茶叶包裹起来塞到冰箱里,能够吸附异味当作除味剂使用。晾干之后掺和到猫砂里头,能协助吸收臭味降低更换频率。煮上一锅茶叶蛋之时放进去染个颜色,起码还能发挥些许余热。
这些用途,都要比喝进自己肚子里,要强上一百倍。记住一个原则,茶叶是花钱买的,这没错,但是你的命可不是。每年,茶叶中毒的案例,在急诊室并不少见,大多数都是舍不得扔,所惹出来的祸。别让几百块的“舍不得”,变成几万块的“治不起”,这笔账,怎么算都不划算。
好茶叶应该怎么存怎么喝
要将买回来的茶叶分装成小份,,每次仅打开一小包,,把其他的密封好放置在阴凉干燥之处。绿茶以及清香乌龙最好放置于冰箱冷藏,,温度设定在0到5度这个区间,,拿出来之后要等恢复到室温才开封,,防止因冷凝水致使受潮。红茶和黑茶能够常温存放,,然而必须避光、密封,,并且远离厨房和卫生间。
要明白最佳饮用期:对于绿茶与花茶而言是半年到一年,红茶则是两到三年,普洱跟黑茶要是存储条件良好能够放置五年以上。倘若超过这个时间段且不存在专业仓储条件,那就应当果断予以处理。要及时饮用好茶,一旦过期便作罢,如此这般才是对自身身体负责的态度。


这些情况千万别犹豫直接扔
茶叶表面呈现出明显霉斑,或者长有白毛,再或者结网的,一秒都不要留存,要直接扔掉。打开包装后闻到刺鼻霉味,或者酸臭味,又或者类似发霉衣服那种味道的,同样要立即进行处理。泡出的茶汤如同泥水那般混浊,或者表面有油膜漂浮的,一口都不要饮用。喝下去之后喉咙发紧,嘴巴发麻,胃里感觉不舒服的,要赶快前往医院检查。
在2020年的时候,浙江有一位大爷,喝了受潮长达半年时间的红茶,三天过后,其肝功能指标急剧飙升,达到了正常值的二十倍之多,随后住院长达半个月,这才好不容易捡回了一条性命。千万不要以为自己身体状况良好,不会扛不住,要知道黄曲霉毒素所带来的损伤是会不断累积的,当下没有出现反应并不意味着就没有造成伤害。对于茶叶这种物品而言,该丢弃的时候就必须丢弃,哪怕只是犹豫一秒钟,那都是对自己不负责任的表现。
你家之中,是否存有搁置许久、未曾饮用的茶叶呢?赶快将其取出,运用这四步方法去检查一番,最终呈现的结果究竟如何,欢迎在评论区域告知于我,若感觉颇具用处,可千万别忘了点赞,并且转发给那些热衷于喝茶的家人以及朋友哟。





发表评论